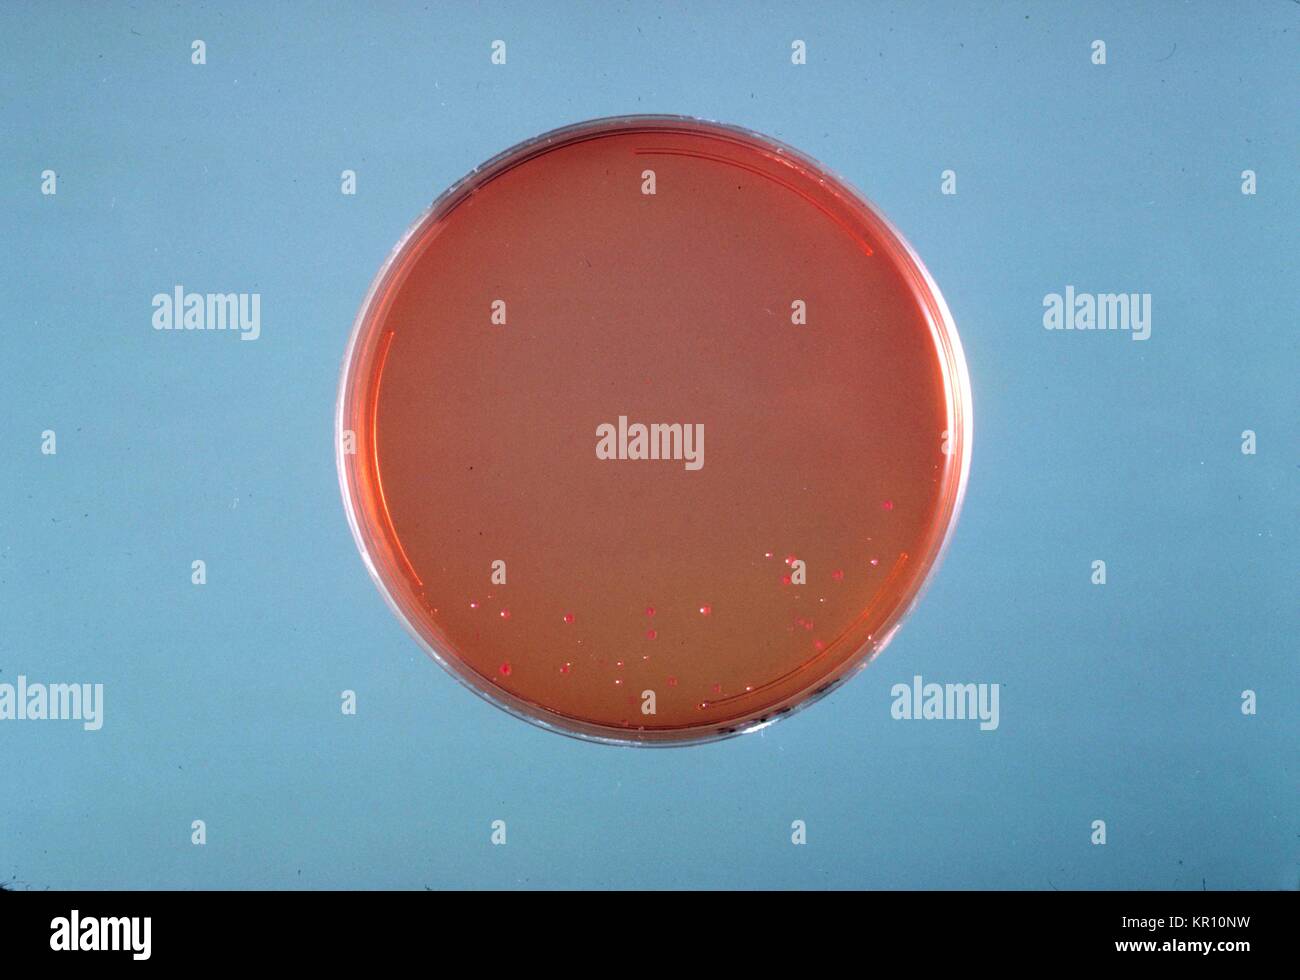
Dies ist ein SS Agarplatte Kultur von Enterobacter sakazakii nach 24 Stunden das Wachstum bei 36<sup> {Grad}</sup> C. Enterobacter sakazakii, ein gram-negative, stabförmige Bakterien, wird von der Familie Enterobacteriaceae, 1978. E. Sakazakii ist mit einer seltenen, aber häufig tödlichen Form der neonatalen Meningitis mit einer Sterblichkeit von 40 bis zu 80 Prozent verbunden. Bild mit freundlicher Genehmigung von CDC/Dr. J.J.Bauer. Stockfoto

Ss 1979 Stockfotos & Bilder

RF2Y0NJFE–Gulfport, MS - 07. Oktober 2023: Low-perspektivische Vorderansicht einer Abholung von Chevrolet El Camino SS aus dem Jahr 1979 bei einer lokalen Autoshow.

RMBGR02W–Nachbildung der Holden LX Torana SS A9X mit dem verstorbenen Peter Brock und Jim Richards gewann 1979 Bathurst 1000

RM2K0E5W4–August Heissmeyer oder Heissmeyer, (11. Januar 1897 - 16. Januar 1979), war während der NS-Zeit ein deutscher SS-Funktionär. Er kommandierte das SS-Hauptbüro in den Jahren 1935-1939. Nach dem Zweiten Weltkrieg wurde Heissmeyer vor Gericht gestellt und als „major Nazi Straftäter“ verurteilt.

RMB849YJ–Blechtrommel Blechtrommel sterben jedes Jahr: 1979 West Deutschland Regie: Volker Schlöndorff Goldene Palme Cannes 1979

RMTBB1T5–Die John PEPERA SAMMLUNG, SS-Obergruppenführer und General der Waffen-SS und der Polizei Friedrich Karl Freiherr von Eberstein - eine Goldene Partei Abzeichen der NSDAP in 30 mm, leicht abgenutzt, vergoldeten Tombak mit beschädigten inset Versilbert emailliert Partei Abzeichen. Partei die Nummer "15067" auf leicht abgenutzt rückwärts mit Stempel eingeprägt 'GES. GESCH." über der horizontalen Stift auf der Befestigungsplatte gestempelt "ESCHLER & SOHN MÜNCHEN 9' über Entlüftungsbohrung. Reproduziert Foto mit original Tinte Signatur. Friedrich Karl Freiherr von Eberstein (14. Januar 1894 in Halle an der Saale - 10. Februar 1979 in Tegernsee), Editorial-Use - Nur
RMKR10NW–Dies ist ein SS Agarplatte Kultur von Enterobacter sakazakii nach 24 Stunden das Wachstum bei 36<sup> {Grad}</sup> C. Enterobacter sakazakii, ein gram-negative, stabförmige Bakterien, wird von der Familie Enterobacteriaceae, 1978. E. Sakazakii ist mit einer seltenen, aber häufig tödlichen Form der neonatalen Meningitis mit einer Sterblichkeit von 40 bis zu 80 Prozent verbunden. Bild mit freundlicher Genehmigung von CDC/Dr. J.J.Bauer.

RMW4H3H2–Vintage 1970's Computer Office Situation mit American Midwest Scientific Instruments Desk Computers Werbung im Kilobaud Microcomputing Magazin 1979 Juni USA die Juni 1979 Ausgabe von Kilobaud Microcomputing enthielt eine bemerkenswerte Werbung für den MSI 6800, einen von Midwest Scientific Instruments, Inc. (MSI) entwickelten Mikrocomputer. In dieser Werbung wurde das MSI 6800 als kompaktes und dennoch leistungsstarkes System vorgestellt, das seine Eignung für wissenschaftliche, pädagogische und geschäftliche Anwendungen unterstreicht

RF2ARHJD8–1973. SS Galileo Galilei überträgt Passagiere in den Hafen. SS Galileo Galilei war ein Ozeandampfer, der 1963 von Cantieri Riuniti dell' Adriatico, Monfalcone, Italien für Lloyd Triestinos Dienst Italien-Australien gebaut wurde. 1979 wurde sie zum Kreuzfahrtschiff umgebaut und fuhr anschließend unter den Namen Galileo und Meridian. Sie sank 1999 in der Straße von Malakka als Sun Vista.

RM2E0R55N–SS-Sergeant Rochus Misch Schalttafelbetreiber im Berliner Bunker Hitlers An der Berliner Mauer mit Blick auf den Bunkerplatz Aus einer Serie von Porträts für das Sunday Times Magazine Zur Illustration von Auszügen aus dem Berliner Bunker von James P O’Donnell

RM3D32NF3–Rom, Italien. November 2025. Die Choreografie mit den Lichtern der Lazio-Fans widmet sich Vincenzo Paparelli, einem Fan, der am 28. Oktober 1979 im Olympiastadion vor dem 10. Spieltag der Serie A Enilive 2025-2026 zwischen SS Lazio gegen Cagliari Calcio im Olympiastadion getötet wurde. Endergebnis Lazio 2: 0 Cagliari Credit: SOPA Images Limited/Alamy Live News

RMED7GYR–Eine "mobile Gallow" derer die SS Häftlinge im Block 11 des Konzentrationslagers Auschwitz in Oswiecim, Polen, 10. Dezember 2014 zu ermorden. Mindestens 1,1 Millionen Häftlinge starben in Auschwitz. Befreiung des Lagers wurde durch sowjetische Truppen am 27. Januar 1945 und wurde 1947 in eine Gedenkstätte und ein Museum umgebaut. Es wurde im Jahr 1979 zum UNESCO-Weltkulturerbe benannt und trägt den Namen Auschwitz-Birkenau - deutschen nationalsozialistischen Konzentrations- und Vernichtungslager Camp seit 2007. Foto: Frank Schumann/Dpa - NO-Draht-Dienst-

RM3D2YRM1–Rom, Italien. November 2025. Rom, Italien 3. November 2025: Die Lazio-Fans erleuchten das Stadion mit dem Namen Vincenzo in Gedenken an den Lazio-Fan, der am 28. Oktober 1979 vor dem 10. Spieltag der Serie A Enilive 2025-2026 im Olympiastadion zwischen SS Lazio und Cagliari Calcio starb. Quelle: Unabhängige Fotoagentur/Alamy Live News

RMFA99GG–1979 - britischer Schauspieler Richard Burton und Marcello Mastroianni den Film '' Tod in Rom '' Entwurf durch das Robert Katz Buch, die den Versuch der Via Rasella in Rom betrifft drehen, wo 33 deutsche Soldaten wurden getötet, und 335 Geiseln wurden bei den ardeatinischen Fosse, nahe der Stadt erschossen. Burton spielt die Rolle des SS-Oberst Manfred Kappler, die Repressalien bestellt, und Marcello Mastroianni spielt die Rolle der Partisanen Priester Don Pietro. Der Film wird unter der Regie von Yorgo Pan Cosmatos (mit Schnurrbart in einigen Fotos) © Keystone Bilder USA/ZUMAPRESS.com/Alamy Live-Nachrichten

RM2FX4HBG–Demonstration mit Transparenten mit den Worten demontieren alle SS-20 und Nr. SS-20 unter anderem, 18. Mai 1979, Botschaften, Demonstrationen, Banner, Niederlande, Foto der Presseagentur des 20. Jahrhunderts, zu erinnerende Nachrichten, Dokumentarfilm, historische Fotografie 1945-1990, visuelle Geschichten, Menschliche Geschichte des zwanzigsten Jahrhunderts, Momente in der Zeit festzuhalten

RM3D32KTG–Rom, Italien. November 2025. Die Choreografie mit den Lichtern der Lazio-Fans widmet sich Vincenzo Paparelli, einem Fan, der am 28. Oktober 1979 im Olympiastadion vor dem 10. Spieltag der Serie A Enilive 2025-2026 zwischen SS Lazio gegen Cagliari Calcio im Olympiastadion getötet wurde. Endergebnis Lazio 2: 0 Cagliari (Foto: Marco Iacobucci/SOPA Images/SIPA USA) Credit: SIPA USA/Alamy Live News

RM2AT38BF–Demonstration der russischen Botschaft in den Haag gegen die Herstellung der SS 20-Rakete Angebot einer Petition Datum: 18. Mai 1979 Ort: Den Haag, Zuid-Holland Schlüsselwörter: Embassaden, Demonstrationen, Petitionen

RM2BFCN40–JOSEF MENGELE (1911-1979) Deutscher SS-Offizier und Arzt in der Mitte mit Richard Bär links und Rudolf Höss rechts. Fotografiert in Solahütte, einem SS-Resort bei Auschwitz Mitte 1844. Baer war Auschwitz-Kommandant ab Mai 1944. Höss war der erste Kommandant.

RMRMTF1J–. Annali del Museo Civico di Storia Naturale Giacomo Doria. Natural History. STENINAE AUS THAILAND 369 weiblich: valvifer denticulate, ohne apico - seitliche Zahn. S Holotyp, 7 SS, 11?? Paratypen: Ufer des Flusses Mae Khong (Mekong) in Chiang Saen, in feinen Schmutz unter Büschen auf Schlamm Fluss, 5.III.1979, G. de Rougemont; 3 SS, 1? Paratypen: Ebd., 29.XII. 1979, G. de Rougemont.. Abb. 11:Stenus puthzianus n. sp. - A: aedeagus; B: Männlich 9 sternite; D: Männlich 8 sternite; E: 9. und 10 tergite. Ann.del Civ. Mus. di St. Nat., Bd. LXXXIII 24. Bitte beachten Sie, dass diese Bilder extrahiert werden fro

RM2WT3CHK–Abruzzen L'Aquila Tagliacozzo SS. Cosma e Damiano4. Hutzel, Max 1960-1990 Außenansicht: Fassade (15. Jahrhundert), Portal zum Innenhof (1452), Fassadenportale und Fenster. Innenansicht: Rippengewölbe, barocke Altäre an den Seiten der kreuzförmigen Kirche, Apsfresko, vergoldetes barockes Tabernakel in Form eines Tempels (18. Jahrhundert), Tabernakelstatuen, Kanzel, Orsini-Wappen, Details von Altargemälden und das Grab von General Conte Resta. Der in Deutschland geborene Fotograf und Gelehrte Max Hutzel (1911–1988) fotografierte in Italien von den frühen 1960er Jahren bis zu seinem Tod. Das Ergebnis

RM2HACBJX–Kraków 04,1979. Starren Sie Miasto. Ulica Grodzka na wysokoœci placu Marii Magdaleny, widok od stony ulice Poselskiej na koœció³ pw. Œwiêtych Aposto³ów Piotra i Paw³a (pojezuicki) (L) i koœció³ pw. œw. Andrzeja (koœció³ klasztorny ss. Klarysek) (w g³êbi). mta PAP/Wojciech Kryñski Dok³adny dzieñ wydarzenia nieustalony. Krakau April 1979. Die Altstadt. Grodzka Straße an der Stelle, an der sie auf den Maria Magdalena Platz trifft; Blick von der Poselska Straße auf die St. Apostel Peter und Paul (post-jesuitische) Kirche (links) und die St. Andrew Kirche (das St. Clair Ordens Kloster) (im Hintergrund). mta

RMMAAECY–. Die Ökologie der Apalachicola Bay System: ein Ästuar- Profil. w "i*O "A" 1^><,^^ Sl_Â" Nt Novem ber^^^^^^^^^^^^ WalacmciaVj APALACMCOm prm -.^^ j '^'^L/â""""/6P4iÂ" d. h | i. uu Wi-^^p*ss^*^E-, ---'^S CUI fvti*^ Dezember lndiMdii; jK pi-r-iMii MJntik-l^u^^ l Tn h Monlli 0,0-2,0 2,0-5,0 5,0-lO.O 10,0 - 15,0 15,0 - 25,0 25,0 -. W.O Abbildung 31. Durchschnittliche monatliche Verteilung der sand Meerforelle (Cynoscion Arenarius) in der Apalachicola Mündung von 1972 bis 1979. 71

RM2K0E42N–Josef Mengele (1911-1979), deutscher SS-Offizier. Foto, das 1956 von einem Polizeifotografen in Buenos Aires für Mengeles argentinisches Ausweisdokument aufgenommen wurde.
![Verbreitung und Häufigkeit Trends von Verteilung und Häufigkeit Trends von 22 ausgewählten Arten im mittleren Atlantik Bucht von Grundschleppnetzen Besichtigungen während 1967-1979: Abschlussbericht an den US-Mineral [s] Management Service distributionabun 1985 Einheit Jahr: 1985 CR-ICH-tr, in dem ich in IE CD zu Il'J2i LU1 1-4 Jo3J 1za J LU 1 dCl CO3 01c'i-u-z LO m â ¢-LO F-J F-M H D H CD-L-llJ â ⢠1/1 U im LL-id CE2UJ M H-D Z U CE01 UJ n CE-CO 1 1 - Id LL m ui in z z o u c âi 30 c â¢â" n 4) = 0 - ≪â o(M U1 Lf) H19 N31 id-lN 33 U] ci: ss Stockfoto Verbreitung und Häufigkeit Trends von Verteilung und Häufigkeit Trends von 22 ausgewählten Arten im mittleren Atlantik Bucht von Grundschleppnetzen Besichtigungen während 1967-1979: Abschlussbericht an den US-Mineral [s] Management Service distributionabun 1985 Einheit Jahr: 1985 CR-ICH-tr, in dem ich in IE CD zu Il'J2i LU1 1-4 Jo3J 1za J LU 1 dCl CO3 01c'i-u-z LO m â ¢-LO F-J F-M H D H CD-L-llJ â ⢠1/1 U im LL-id CE2UJ M H-D Z U CE01 UJ n CE-CO 1 1 - Id LL m ui in z z o u c âi 30 c â¢â" n 4) = 0 - ≪â o(M U1 Lf) H19 N31 id-lN 33 U] ci: ss Stockfoto](https://c8.alamy.com/compde/t1h235/verbreitung-und-haufigkeit-trends-von-verteilung-und-haufigkeit-trends-von-22-ausgewahlten-arten-im-mittleren-atlantik-bucht-von-grundschleppnetzen-besichtigungen-wahrend-1967-1979-abschlussbericht-an-den-us-mineral-s-management-service-distributionabun-1985-einheit-jahr-1985-cr-ich-tr-in-dem-ich-in-ie-cd-zu-ilj2i-lu1-1-4-jo3j-1za-j-lu-1-dcl-co3-01ci-u-z-lo-m-lo-f-j-f-m-h-d-h-cd-l-llj-11-u-im-ll-id-ce2uj-m-h-d-z-u-ce01-uj-n-ce-co-1-1-id-ll-m-ui-in-z-z-o-u-c-i-30-c-n-4-=-0-lt-om-u1-lf-h19-n31-id-ln-33-u-ci-ss-t1h235.jpg)
RMT1H235–Verbreitung und Häufigkeit Trends von Verteilung und Häufigkeit Trends von 22 ausgewählten Arten im mittleren Atlantik Bucht von Grundschleppnetzen Besichtigungen während 1967-1979: Abschlussbericht an den US-Mineral [s] Management Service distributionabun 1985 Einheit Jahr: 1985 CR-ICH-tr, in dem ich in IE CD zu Il'J2i LU1 1-4 Jo3J 1za J LU 1 dCl CO3 01c'i-u-z LO m â ¢-LO F-J F-M H D H CD-L-llJ â ⢠1/1 U im LL-id CE2UJ M H-D Z U CE01 UJ n CE-CO 1 1 - Id LL m ui in z z o u c âi 30 c â¢â" n 4) = 0 - ≪â o(M U1 Lf) H19 N31 id-lN 33 U] ci: ss

RMTBB1T4–Die John PEPERA SAMMLUNG, SS-Obergruppenführer und General der Waffen-SS und der Polizei Friedrich Karl Freiherr von Eberstein - eine Goldene Partei Abzeichen der NSDAP in 30 mm, leicht abgenutzt, vergoldeten Tombak mit beschädigten inset Versilbert emailliert Partei Abzeichen. Partei die Nummer "15067" auf leicht abgenutzt rückwärts mit Stempel eingeprägt 'GES. GESCH." über der horizontalen Stift auf der Befestigungsplatte gestempelt "ESCHLER & SOHN MÜNCHEN 9' über Entlüftungsbohrung. Reproduziert Foto mit original Tinte Signatur. Friedrich Karl Freiherr von Eberstein (14. Januar 1894 in Halle an der Saale - 10. Februar 1979 in Tegernsee), Editorial-Use - Nur

RMKR12TJ–Diese photomicrograph zeigt Bacteroides fragilis ss, 1972. vulgatus nach kultivierten, in einem thioglycollate Medium für 48 Stunden. Mitglieder der Gattungen Bacteroides sind anaerobe Gram-negative Bakterien, die vor allem im Darm als normale Flora gefunden werden. Es kann jedoch opportunistische unter entsprechenden prädisponierenden Faktoren wie Immunsuppression, Gewebeschäden, Krebserkrankung, etc. Mit freundlicher Genehmigung CDC / Dr. werden V. R. Dowell, jr.

RM2E0R55G–SS-Sergeant Rochus Misch Schalttafelbetreiber im Berliner Bunker Hitlers An der Berliner Mauer mit Blick auf den Bunkerplatz Aus einer Serie von Porträts für das Sunday Times Magazine Zur Illustration von Auszügen aus dem Berliner Bunker von James P O’Donnell

RMED7GYX–Besucher der Ruinen von Krematorium und der Gaskammer II des Konzentrationslagers Auschwitz-Birkenau sind in Oswiecim, Polen, 4. Oktober 2014 gesehen. Die Kaserne der Frauenlager sind im Hintergrund zu sehen. SS-Truppen haben versucht, ihre Verbrechen vertuschen, durch Sprengung des Krematoriums und der Gaskammer während des deutschen Rückzugs im Januar 1945. Befreiung des Lagers wurde durch sowjetische Truppen am 27. Januar 1945 und wurde 1947 in eine Gedenkstätte und ein Museum umgebaut. Es wurde im Jahr 1979 zum UNESCO-Weltkulturerbe benannt und trägt den Namen Auschwitz-Birkenau - deutschen nationalsozialistischen Konzentrations- und Vernichtungslager Camp

RMF4B9EX–1979 - NS-Prozess In München/West Deutschland Kurt Christmann an das Schwurgericht: vermutlich einer der letzten NS-Prozesse vollziehen sich zur Zeit in München, die Beklagte ist Kurt Christmann. Der 73 Jahre alte ehemalige unbeweglichen Geschäftsmann soll ein Mörder in drei Fällen mit nicht weniger als 105 Tote gewesen sein. Während des Krieges in Russland als "SS-Obersturmbannfuhrer" hat er den Massenmörder von Juden und anderen Personen mit der Zusammenarbeit von anderen Menschen, bewacht, bestellt und in einem Fall er hat dazu beigetragen, die Tötung mit eigener Hand. 1971 gab es bevorzugt eine Anklage gegen Christmann,

RMGX9R70–Polen. Danzig. Denkmal für die Verteidiger der polnischen Post. Entworfen von Wincenty Kucma (geb. 1935). Es handelt sich um einen sterbenden polnische Post-Mitarbeiter, der eine Gewehr von Nike übergeben wird. Detail.

RM2FX4HBH–Demonstration mit Transparenten, auf denen unter anderem die SS-20 und die SS-20 demontiert wurden, 18. Mai 1979, Botschaften, Demonstrationen, Banner, Niederlande, Foto der Presseagentur des 20. Jahrhunderts, zu erinnerende Nachrichten, Dokumentarfilm, historische Fotografie 1945-1990, visuelle Geschichten, Menschliche Geschichte des zwanzigsten Jahrhunderts, Momente in der Zeit festzuhalten

RM2APJJ41–Demonstration für die russische Botschaft in den Haag gegen die Herstellung der SS 20-Rakete Beschreibung: Demonstration mit Bannern, auf denen der Text Alle SS-20 und SS-20 Demontieren Datum: 18. Mai 1979 Ort: Den Haag, Zuid-Holland Schlüsselwörter: Botschaften, Demonstrationen, Banner

RMP7B521–Polen. Danzig. Denkmal der Verteidigung der Polnischen Post in Danzig (Gdansk). Entworfen von wincenty Kucma stellt eine sterbende Polnische Post Mitarbeiter übergeben ein Gewehr von Nike ein wenig zu spät. Detail.

RMRHN1Y4–. Die biologische Bulletin. Biologie; Zoologie; Biologie; Meeresbiologie. B ABBILDUNG 11. Schaltpläne der Linse Fibre Zellmembranen. A. in der Vereinigung der in Wasser unlöslichen aber Harnstoff-lösliche Proteine mit der Faser Zellmembran, und eine Zusammenfassung der anderen assoziierten molekularen Arten (nach Broekhuyse, 1981). B. in der Assoziation der 43.000 Dalton wasserlösliches Protein, die mit dem Objektiv Fibre Zellmembran, und Aggregation von anderen löslichen crystallins auf die Membran über-SS Bonding (nach Spector et al., 1979).. Bitte beachten Sie, dass diese Bilder aus gescannten Seite Bilder, die digital verbesserte fo wurden extrahiert werden

RM2WT5YXW–Abruzzen L'Aquila Tagliacozzo SS. Cosma e Damiano3. Hutzel, Max 1960-1990 Außenansicht: Fassade (15. Jahrhundert), Portal zum Innenhof (1452), Fassadenportale und Fenster. Innenansicht: Rippengewölbe, barocke Altäre an den Seiten der kreuzförmigen Kirche, Apsfresko, vergoldetes barockes Tabernakel in Form eines Tempels (18. Jahrhundert), Tabernakelstatuen, Kanzel, Orsini-Wappen, Details von Altargemälden und das Grab von General Conte Resta. Der in Deutschland geborene Fotograf und Gelehrte Max Hutzel (1911–1988) fotografierte in Italien von den frühen 1960er Jahren bis zu seinem Tod. Das Ergebnis
![. 1 r-2; • 1/⢠i".-: â ¢. jiin r?V R (-*-. v -. 1 eJ Vr: - - â'.â¢â". ' S f|V'' Ich 1 - â â¢-] Ich r^ Ss? 1 â â J d? § K a) n'La* fl UB' Q/V "ac gehen Rp, J-O& - "flfnUfll â ¢â.- JSÂ"? Uu< 'nnn' H^r3, der mit einem V. Ti raSM, U^o6L01/;..; L .. ', ',' Q H [Ti;. 0 o n'       1 '..'J------- M i:, ≪55. D • Abbildung 3.1. Frühling Distribution, 1968-1979, 69 Stockfoto . 1 r-2; • 1/⢠i".-: â ¢. jiin r?V R (-*-. v -. 1 eJ Vr: - - â'.â¢â". ' S f|V'' Ich 1 - â â¢-] Ich r^ Ss? 1 â â J d? § K a) n'La* fl UB' Q/V "ac gehen Rp, J-O& - "flfnUfll â ¢â.- JSÂ"? Uu< 'nnn' H^r3, der mit einem V. Ti raSM, U^o6L01/;..; L .. ', ',' Q H [Ti;. 0 o n'       1 '..'J------- M i:, ≪55. D • Abbildung 3.1. Frühling Distribution, 1968-1979, 69 Stockfoto](https://c8.alamy.com/compde/mckrte/1-r-2-1-i-jiin-rv-r-v-1-ej-vr-s-fv-ich-1-ich-r-ss-1-j-d-k-a-nla-fl-ub-qv-ac-gehen-rp-j-oamp-flfnufll-js-uult-nnn-hr3-der-mit-einem-v-ti-rasm-uo6l01-l-q-h-ti-0-o-n-1-j-m-i-lt55-d-abbildung-31-fruhling-distribution-1968-1979-69-mckrte.jpg)
RMMCKRTE–. 1 r-2; • 1/⢠i".-: â ¢. jiin r?V R (-*-. v -. 1 eJ Vr: - - â'.â¢â"._' S f|V'' Ich 1 - â â¢-] Ich r^ Ss? 1 â â J d? § K a) n'La* fl UB' Q/V "ac gehen Rp, J-O& - "flfnUfll â ¢â.-_JSÂ"? Uu< 'nnn' H^r3, der mit einem V. Ti raSM, U^o6L01/;..; L .. ~', ',~' Q H [Ti;. _0 o n'       1_'..'J------- M i:, ≪55. D • Abbildung 3.1. Frühling Distribution, 1968-1979, 69

RM2A25YC9–Foto von Dr. Josef Mengele. Josef Mengele (1911-1979) ein deutsches Schutzstaffel (SS) Offizier und Arzt im KZ Auschwitz während des Zweiten Weltkrieges.

RMTBB1T6–Die John PEPERA SAMMLUNG, SS-Obergruppenführer und General der Waffen-SS und der Polizei Friedrich Karl Freiherr von Eberstein - eine Goldene Partei Abzeichen der NSDAP in 30 mm, leicht abgenutzt, vergoldeten Tombak mit beschädigten inset Versilbert emailliert Partei Abzeichen. Partei die Nummer "15067" auf leicht abgenutzt rückwärts mit Stempel eingeprägt 'GES. GESCH." über der horizontalen Stift auf der Befestigungsplatte gestempelt "ESCHLER & SOHN MÜNCHEN 9' über Entlüftungsbohrung. Reproduziert Foto mit original Tinte Signatur. Friedrich Karl Freiherr von Eberstein (14. Januar 1894 in Halle an der Saale - 10. Februar 1979 in Tegernsee), Editorial-Use - Nur

RMKR0YFC–Diese Aufnahme zeigt Bacteroides fragilis ss, 1972. Fragilis kultivierten Bakterien im Blut agar Medium für 48 Stunden. Gram-negative B. fragilis, obwohl ein kommensalen Bakterien, die normalerweise in den menschlichen Magen-Darm-Trakt lebt, unter Umständen Krankheitserreger können bei Störung der normalen Darmschleimhaut wie Trauma oder Chirurgie geworden. Bild mit freundlicher Genehmigung von CDC/Dr. V.R. Dowell, jr.

RMED7KBX–Oswiecim, Polen. 10. Dezember 2014. Eine "mobile Gallow" derer die SS Häftlinge im Block 11 des Konzentrationslagers Auschwitz in Oswiecim, Polen, 10. Dezember 2014 zu ermorden. Mindestens 1,1 Millionen Häftlinge starben in Auschwitz. Befreiung des Lagers wurde durch sowjetische Truppen am 27. Januar 1945 und wurde 1947 in eine Gedenkstätte und ein Museum umgebaut. Es wurde im Jahr 1979 zum UNESCO-Weltkulturerbe benannt und trägt den Namen Auschwitz-Birkenau - deutschen nationalsozialistischen Konzentrations- und Vernichtungslager Camp seit 2007. Foto: Frank Schumann/Dpa - NO-Draht-SERVICE-/ Dpa/Alamy Live News

RM2K383T9–Newark, Delaware, USA. 25. September 2022. Hampton Quarterback MALCOLM MAYS (7) in Aktion während eines vierwöchigen Spiels zwischen den Delaware Blue Hennen und den Hampton Pirates Samstag, 24. September 2022; im Tubby Raymond Field im Delaware Stadium in Newark, DE. (Bild: © Saquan Stimpson/ZUMA Press Wire)

RMGX9R78–Polen. Danzig. Denkmal für die Verteidiger der polnischen Post. Entworfen von Wincenty Kucma (geb. 1935). Es handelt sich um einen sterbenden polnische Post-Mitarbeiter, der eine Gewehr von Nike übergeben wird.

RM2APJJ49–Demonstration für die russische Botschaft in den Haag gegen die Herstellung der SS 20-Rakete Beschreibung: Demonstration mit Bannern, auf denen der Text Alle SS-20 und SS-20 Demontieren Datum: 18. Mai 1979 Ort: Den Haag, Zuid-Holland Schlüsselwörter: Botschaften, Demonstrationen, Banner

RMP7B51W–Polen. Danzig. Denkmal der Verteidigung der Polnischen Post in Danzig (Gdansk). Entworfen von wincenty Kucma stellt eine sterbende Polnische Post Mitarbeiter übergeben ein Gewehr von Nike ein wenig zu spät. Detail.
![. Cladoniae herbariorum Floerke et Robert Basic. Bildliche Werke; Flo?rke, Heinrich Gustav, 1764-1835; Robert Basic, Friedrich Wilhelm, 1792-1857; Cladonia; Flechten. /Tr> ich Ss, "J^* •. /O''.fr .. Bitte beachten Sie, dass diese Bilder sind von der gescannten Seite Bilder, die digital für die Lesbarkeit verbessert haben mögen - Färbung und Aussehen dieser Abbildungen können nicht perfekt dem Original ähneln. extrahiert. Arnold, F. (Ferdinand), 1828-1901; Arnold, F. (Ferdinand), 1828-1901. Exsiccati Lichenes; Stevenson, John A. (Johannes Albert), 1890-1979, der ehemalige Eigentümer. DSI. [München? : Der Autor?] Stockfoto . Cladoniae herbariorum Floerke et Robert Basic. Bildliche Werke; Flo?rke, Heinrich Gustav, 1764-1835; Robert Basic, Friedrich Wilhelm, 1792-1857; Cladonia; Flechten. /Tr> ich Ss, "J^* •. /O''.fr .. Bitte beachten Sie, dass diese Bilder sind von der gescannten Seite Bilder, die digital für die Lesbarkeit verbessert haben mögen - Färbung und Aussehen dieser Abbildungen können nicht perfekt dem Original ähneln. extrahiert. Arnold, F. (Ferdinand), 1828-1901; Arnold, F. (Ferdinand), 1828-1901. Exsiccati Lichenes; Stevenson, John A. (Johannes Albert), 1890-1979, der ehemalige Eigentümer. DSI. [München? : Der Autor?] Stockfoto](https://c8.alamy.com/compde/rekpgc/cladoniae-herbariorum-floerke-et-robert-basic-bildliche-werke-florke-heinrich-gustav-1764-1835-robert-basic-friedrich-wilhelm-1792-1857-cladonia-flechten-trgt-ich-ss-j-ofr-bitte-beachten-sie-dass-diese-bilder-sind-von-der-gescannten-seite-bilder-die-digital-fur-die-lesbarkeit-verbessert-haben-mogen-farbung-und-aussehen-dieser-abbildungen-konnen-nicht-perfekt-dem-original-ahneln-extrahiert-arnold-f-ferdinand-1828-1901-arnold-f-ferdinand-1828-1901-exsiccati-lichenes-stevenson-john-a-johannes-albert-1890-1979-der-ehemalige-eigentumer-dsi-munchen-der-autor-rekpgc.jpg)
RMREKPGC–. Cladoniae herbariorum Floerke et Robert Basic. Bildliche Werke; Flo?rke, Heinrich Gustav, 1764-1835; Robert Basic, Friedrich Wilhelm, 1792-1857; Cladonia; Flechten. /Tr> ich Ss, "J^* •. /O''.fr .. Bitte beachten Sie, dass diese Bilder sind von der gescannten Seite Bilder, die digital für die Lesbarkeit verbessert haben mögen - Färbung und Aussehen dieser Abbildungen können nicht perfekt dem Original ähneln. extrahiert. Arnold, F. (Ferdinand), 1828-1901; Arnold, F. (Ferdinand), 1828-1901. Exsiccati Lichenes; Stevenson, John A. (Johannes Albert), 1890-1979, der ehemalige Eigentümer. DSI. [München? : Der Autor?]

RM2WT8DWM–Abruzzen L'Aquila Tagliacozzo SS. Cosma e Damiano2. Hutzel, Max 1960-1990 Außenansicht: Fassade (15. Jahrhundert), Portal zum Innenhof (1452), Fassadenportale und Fenster. Innenansicht: Rippengewölbe, barocke Altäre an den Seiten der kreuzförmigen Kirche, Apsfresko, vergoldetes barockes Tabernakel in Form eines Tempels (18. Jahrhundert), Tabernakelstatuen, Kanzel, Orsini-Wappen, Details von Altargemälden und das Grab von General Conte Resta. Der in Deutschland geborene Fotograf und Gelehrte Max Hutzel (1911–1988) fotografierte in Italien von den frühen 1960er Jahren bis zu seinem Tod. Das Ergebnis
![Ein Geschenk der Ehre von Hermann Fegelein (1906-1945), SS-Brigadeführer Wilhelm Bittrich (1894-1979) Reiterstandbild von Versilberten Zinkdruckguss, mit der Darstellung eines Kavallerist zu Beginn der 1930er Jahre. Die Basis ist graviert (tr) 'DEDICATED von ganzem Herzen zum SS-Brigadeführer Wilhelm Bittrich auf [seine] Übernahme der SS-Kavallerie Brigade am 1. Mai 1942. Fegelein". An diesem Punkt in der Zeit, Wilhelm Bittrich wurde im Auftrag der 8. SS Cavalry Division Florian Geyer' aus der SS-Kavallerie Brigade zu bilden. Fegelein, damals Inspektor der montiert und Verkehrsmittel in Th, Editorial-Use - Nur Stockfoto Ein Geschenk der Ehre von Hermann Fegelein (1906-1945), SS-Brigadeführer Wilhelm Bittrich (1894-1979) Reiterstandbild von Versilberten Zinkdruckguss, mit der Darstellung eines Kavallerist zu Beginn der 1930er Jahre. Die Basis ist graviert (tr) 'DEDICATED von ganzem Herzen zum SS-Brigadeführer Wilhelm Bittrich auf [seine] Übernahme der SS-Kavallerie Brigade am 1. Mai 1942. Fegelein". An diesem Punkt in der Zeit, Wilhelm Bittrich wurde im Auftrag der 8. SS Cavalry Division Florian Geyer' aus der SS-Kavallerie Brigade zu bilden. Fegelein, damals Inspektor der montiert und Verkehrsmittel in Th, Editorial-Use - Nur Stockfoto](https://c8.alamy.com/compde/t837cp/ein-geschenk-der-ehre-von-hermann-fegelein-1906-1945-ss-brigadefuhrer-wilhelm-bittrich-1894-1979-reiterstandbild-von-versilberten-zinkdruckguss-mit-der-darstellung-eines-kavallerist-zu-beginn-der-1930er-jahre-die-basis-ist-graviert-tr-dedicated-von-ganzem-herzen-zum-ss-brigadefuhrer-wilhelm-bittrich-auf-seine-ubernahme-der-ss-kavallerie-brigade-am-1-mai-1942-fegelein-an-diesem-punkt-in-der-zeit-wilhelm-bittrich-wurde-im-auftrag-der-8-ss-cavalry-division-florian-geyer-aus-der-ss-kavallerie-brigade-zu-bilden-fegelein-damals-inspektor-der-montiert-und-verkehrsmittel-in-th-editorial-use-nur-t837cp.jpg)
RMT837CP–Ein Geschenk der Ehre von Hermann Fegelein (1906-1945), SS-Brigadeführer Wilhelm Bittrich (1894-1979) Reiterstandbild von Versilberten Zinkdruckguss, mit der Darstellung eines Kavallerist zu Beginn der 1930er Jahre. Die Basis ist graviert (tr) 'DEDICATED von ganzem Herzen zum SS-Brigadeführer Wilhelm Bittrich auf [seine] Übernahme der SS-Kavallerie Brigade am 1. Mai 1942. Fegelein". An diesem Punkt in der Zeit, Wilhelm Bittrich wurde im Auftrag der 8. SS Cavalry Division Florian Geyer' aus der SS-Kavallerie Brigade zu bilden. Fegelein, damals Inspektor der montiert und Verkehrsmittel in Th, Editorial-Use - Nur

RMKR0YCT–Diese Aufnahme zeigt Bacteroides fragilis ss, 1972. Ovatus kultivierten Bakterien im Blut agar Medium für 48 Stunden. Gram-negative B. ovatus, kommensalen Bakterien, die normalerweise in den menschlichen Magen-Darm-Trakt lebt unter Umständen mit Störung der normalen Darmschleimhaut wie Trauma oder Chirurgie pathogene werden kann. Bild mit freundlicher Genehmigung von CDC/Dr. V.R. Dowell, jr.

RMED7GYP–Besucher der Ruinen von Krematorium und der Gaskammer II des Konzentrationslagers Auschwitz-Birkenau sind am 4. Oktober 2014 gesehen. Die Kaserne der Frauenlager sind im Hintergrund zu sehen. SS-Truppen haben versucht, ihre Verbrechen vertuschen, durch Sprengung des Krematoriums und der Gaskammer während des deutschen Rückzugs im Januar 1945. Befreiung des Lagers wurde durch sowjetische Truppen am 27. Januar 1945 und wurde 1947 in eine Gedenkstätte und ein Museum umgebaut. Es wurde im Jahr 1979 zum UNESCO-Weltkulturerbe benannt und trägt den Namen Auschwitz-Birkenau - deutschen nationalsozialistischen Konzentrations- und Vernichtungslager Camp seit 2007. Foto

RMGX9R7D–Polen. Danzig. Denkmal für die Verteidiger der polnischen Post. Entworfen von Wincenty Kucma (geb. 1935). Es handelt sich um einen sterbenden polnische Post-Mitarbeiter, der eine Gewehr von Nike übergeben wird. Detail.

RMP7B51Y–Polen. Danzig. Denkmal für die Verteidiger der polnischen Post. Entworfen von Wincenty Kucma (geb. 1935). Es handelt sich um einen sterbenden polnische Post-Mitarbeiter, der eine Gewehr von Nike übergeben wird.

RMRJRCRN–. Die australische Zoologe. Zoologie; Zoologie; Zoologie. "*SS? W^© B Abb. 1. Phasen der Litoria chloris A. Stadium 20 (neu - schraffiert). B&C Stufe 29. Die Bar in jedem Fall entspricht 1 mm.. ^^rzrrT ^m^^== 260 Aust. Zool. 20 (2), 1979. Bitte beachten Sie, dass diese Bilder sind von der gescannten Seite Bilder, die digital für die Lesbarkeit verbessert haben mögen - Färbung und Aussehen dieser Abbildungen können nicht perfekt dem Original ähneln. extrahiert. Royal zoologischen Gesellschaft von New South Wales; Königliche Zoologische Gesellschaft von New South Wales. Verfahren. [Sydney, Royal Zoological Socie

RM2WT33XB–Abruzzen L'Aquila Tagliacozzo SS. Cosma e Damiano0. Hutzel, Max 1960-1990 Außenansicht: Fassade (15. Jahrhundert), Portal zum Innenhof (1452), Fassadenportale und Fenster. Innenansicht: Rippengewölbe, barocke Altäre an den Seiten der kreuzförmigen Kirche, Apsfresko, vergoldetes barockes Tabernakel in Form eines Tempels (18. Jahrhundert), Tabernakelstatuen, Kanzel, Orsini-Wappen, Details von Altargemälden und das Grab von General Conte Resta. Der in Deutschland geborene Fotograf und Gelehrte Max Hutzel (1911–1988) fotografierte in Italien von den frühen 1960er Jahren bis zu seinem Tod. Das Ergebnis
![Ein Geschenk der Ehre von Hermann Fegelein (1906-1945), SS-Brigadeführer Wilhelm Bittrich (1894-1979) Reiterstandbild von Versilberten Zinkdruckguss, mit der Darstellung eines Kavallerist zu Beginn der 1930er Jahre. Die Basis ist graviert (tr) 'DEDICATED von ganzem Herzen zum SS-Brigadeführer Wilhelm Bittrich auf [seine] Übernahme der SS-Kavallerie Brigade am 1. Mai 1942. Fegelein". An diesem Punkt in der Zeit, Wilhelm Bittrich wurde im Auftrag der 8. SS Cavalry Division Florian Geyer' aus der SS-Kavallerie Brigade zu bilden. Fegelein, damals Inspektor der montiert und Verkehrsmittel in Th, Editorial-Use - Nur Stockfoto Ein Geschenk der Ehre von Hermann Fegelein (1906-1945), SS-Brigadeführer Wilhelm Bittrich (1894-1979) Reiterstandbild von Versilberten Zinkdruckguss, mit der Darstellung eines Kavallerist zu Beginn der 1930er Jahre. Die Basis ist graviert (tr) 'DEDICATED von ganzem Herzen zum SS-Brigadeführer Wilhelm Bittrich auf [seine] Übernahme der SS-Kavallerie Brigade am 1. Mai 1942. Fegelein". An diesem Punkt in der Zeit, Wilhelm Bittrich wurde im Auftrag der 8. SS Cavalry Division Florian Geyer' aus der SS-Kavallerie Brigade zu bilden. Fegelein, damals Inspektor der montiert und Verkehrsmittel in Th, Editorial-Use - Nur Stockfoto](https://c8.alamy.com/compde/t837cw/ein-geschenk-der-ehre-von-hermann-fegelein-1906-1945-ss-brigadefuhrer-wilhelm-bittrich-1894-1979-reiterstandbild-von-versilberten-zinkdruckguss-mit-der-darstellung-eines-kavallerist-zu-beginn-der-1930er-jahre-die-basis-ist-graviert-tr-dedicated-von-ganzem-herzen-zum-ss-brigadefuhrer-wilhelm-bittrich-auf-seine-ubernahme-der-ss-kavallerie-brigade-am-1-mai-1942-fegelein-an-diesem-punkt-in-der-zeit-wilhelm-bittrich-wurde-im-auftrag-der-8-ss-cavalry-division-florian-geyer-aus-der-ss-kavallerie-brigade-zu-bilden-fegelein-damals-inspektor-der-montiert-und-verkehrsmittel-in-th-editorial-use-nur-t837cw.jpg)
RMT837CW–Ein Geschenk der Ehre von Hermann Fegelein (1906-1945), SS-Brigadeführer Wilhelm Bittrich (1894-1979) Reiterstandbild von Versilberten Zinkdruckguss, mit der Darstellung eines Kavallerist zu Beginn der 1930er Jahre. Die Basis ist graviert (tr) 'DEDICATED von ganzem Herzen zum SS-Brigadeführer Wilhelm Bittrich auf [seine] Übernahme der SS-Kavallerie Brigade am 1. Mai 1942. Fegelein". An diesem Punkt in der Zeit, Wilhelm Bittrich wurde im Auftrag der 8. SS Cavalry Division Florian Geyer' aus der SS-Kavallerie Brigade zu bilden. Fegelein, damals Inspektor der montiert und Verkehrsmittel in Th, Editorial-Use - Nur

RMKR0XRX–Diese Aufnahme zeigt Bacteroides fragilis ss, 1972. Fragilis kultivierten Bakterien im Blut agar Medium für 48 Stunden. Gram-negative B. fragilis, obwohl ein kommensalen Bakterien, die normalerweise in den menschlichen Verdauungstrakt Leben dieses Organismus unter Umständen Krankheitserreger können bei Störung der normalen Darmschleimhaut wie Trauma oder Chirurgie geworden. Bild mit freundlicher Genehmigung von CDC/Dr. V.R. Dowell, jr.

RMGX9R6R–Polen. Danzig. Denkmal für die Verteidiger der polnischen Post. Entworfen von Wincenty Kucma (geb. 1935). Es handelt sich um einen sterbenden polnische Post-Mitarbeiter, der eine Gewehr von Nike übergeben wird.

RMP7B51J–Polen. Danzig. Denkmal für die Verteidiger der polnischen Post. Entworfen von Wincenty Kucma (geb. 1935). Es handelt sich um einen sterbenden polnische Post-Mitarbeiter, der eine Gewehr von Nike übergeben wird.

RMRE04EA–. Die Ökologie der Apalachicola Bay System: ein Ästuar- Profil. Mündungs- Ökologie - Florida Apalachicola Bucht; Mündungs- Bereich Erhaltung - Florida. w "i*O "A" 1^><,^^ Sl_Â" Nt Novem ber^^^^^^^^^^^^ WalacmciaVj APALACMCOm prm -.^^ j '^'^L/â""""/6P4iÂ" d. h | i. uu Wi-^^p*ss^*^E-, ---'^S CUI fvti*^ Dezember lndiMdii; jK pi-r-iMii MJntik-l^u^^ l Tn h Monlli 0,0-2,0 2,0-5,0 5,0-lO.O 10,0 - 15,0 15,0 - 25,0 25,0 -. W.O Abbildung 31. Durchschnittliche monatliche Verteilung der sand Meerforelle (Cynoscion Arenarius) in der Apalachicola Mündung von 1972 bis 1979. 71.

RM2WT4YH9–Abruzzen L'Aquila Tagliacozzo SS. Cosma e Damiano7. Hutzel, Max 1960-1990 Außenansicht: Fassade (15. Jahrhundert), Portal zum Innenhof (1452), Fassadenportale und Fenster. Innenansicht: Rippengewölbe, barocke Altäre an den Seiten der kreuzförmigen Kirche, Apsfresko, vergoldetes barockes Tabernakel in Form eines Tempels (18. Jahrhundert), Tabernakelstatuen, Kanzel, Orsini-Wappen, Details von Altargemälden und das Grab von General Conte Resta. Der in Deutschland geborene Fotograf und Gelehrte Max Hutzel (1911–1988) fotografierte in Italien von den frühen 1960er Jahren bis zu seinem Tod. Das Ergebnis

RMTBB1T9–Die John PEPERA SAMMLUNG, SS-Obergruppenführer August Heissmeyer - ein übereinstimmendes Paar der Goldenen Partei Abzeichen der NSDAP, Deschler produziert 30 mm vergoldete Tombak mit Einfügung Versilbert emailliert Partei Abzeichen. Partei die Nummer "21573" auf der Rückseite mit vertikalen Pin. Gestempelt incuse' GES. GESCH." über Kanal- und Entlüftungsöffnung. 24 mm der gleichen Bau, den Zustand und die entsprechende Nummer auf der Rückseite mit horizontalen Stift. Anhang Typenschild 'Jos. Fuess München'. August Heissmeyer (oder Heißmeyer - 11 Januar 1897 in Gellersen - 16 Januar 1979 in Schwäbisch Hall), war einer der führenden Memb, Editorial-Use - Nur

RMRJCXAP–. Die wechselnden Illinois Umwelt: kritische Trends: Technischer Bericht der kritischen Trends Bewertung Projekt. Mann; Verschmutzung; Umweltschutz; Ökologie; Umweltverträglichkeitsprüfung. Die atmosphärische Deposition TRENDS IN ILLINOIS 19 18 78 11 CO UJ CO CO o z = j 99 47 35 63^^ NASS DEPO &Amp; DRYFALL NASS DEPO, DRYFALL& V. NASS DEPO NUR NASS DEPO TRENDS: ^^^^^^^^^^^^ SS>^^^^ S^^^:^^^^^^^:^^^^^^^:^^^^^ S^^. ____ Ji 1979 1981 1983 1985 1987 Jahr 1989 1991 Abbildung 2. Aufzeichnung von nassen und trockenen Deposition Messungen am Illinois Seiten (siehe Abbildung I für Standorte). Nasse Deposition (WET DEPO) und dr

RM2WT593H–Abruzzen L'Aquila Tagliacozzo SS. Cosma e Damiano5. Hutzel, Max 1960-1990 Außenansicht: Fassade (15. Jahrhundert), Portal zum Innenhof (1452), Fassadenportale und Fenster. Innenansicht: Rippengewölbe, barocke Altäre an den Seiten der kreuzförmigen Kirche, Apsfresko, vergoldetes barockes Tabernakel in Form eines Tempels (18. Jahrhundert), Tabernakelstatuen, Kanzel, Orsini-Wappen, Details von Altargemälden und das Grab von General Conte Resta. Der in Deutschland geborene Fotograf und Gelehrte Max Hutzel (1911–1988) fotografierte in Italien von den frühen 1960er Jahren bis zu seinem Tod. Das Ergebnis

RMTBB1T8–Die John PEPERA SAMMLUNG, SS-Obergruppenführer August Heissmeyer - ein übereinstimmendes Paar der Goldenen Partei Abzeichen der NSDAP, Deschler produziert 30 mm vergoldete Tombak mit Einfügung Versilbert emailliert Partei Abzeichen. Partei die Nummer "21573" auf der Rückseite mit vertikalen Pin. Gestempelt incuse' GES. GESCH." über Kanal- und Entlüftungsöffnung. 24 mm der gleichen Bau, den Zustand und die entsprechende Nummer auf der Rückseite mit horizontalen Stift. Anhang Typenschild 'Jos. Fuess München'. August Heissmeyer (oder Heißmeyer - 11 Januar 1897 in Gellersen - 16 Januar 1979 in Schwäbisch Hall), war einer der führenden Memb, Editorial-Use - Nur

RMRCDG22–. Die stoffliche Grundlage der Vererbung. Vererbung ist. c^ ss ^d^4^^i^e^%. iX% - •^'/f i s^J r^^^".> *^r^^.. Bitte beachten Sie, dass diese Bilder sind von der gescannten Seite Bilder, die digital für die Lesbarkeit verbessert haben mögen - Färbung und Aussehen dieser Abbildungen können nicht perfekt dem Original ähneln. extrahiert. Morgan, Thomas Hunt, 1866-1945; Nachtsheim, Hans, 1890-1979. Borntraeger Berlin: G.

RM2WT2XX7–Abruzzen L'Aquila Tagliacozzo SS. Cosma e Damiano2. Hutzel, Max 1960-1990 Außenansicht: Fassade (15. Jahrhundert), Portal zum Innenhof (1452), Fassadenportale und Fenster. Innenansicht: Rippengewölbe, barocke Altäre an den Seiten der kreuzförmigen Kirche, Apsfresko, vergoldetes barockes Tabernakel in Form eines Tempels (18. Jahrhundert), Tabernakelstatuen, Kanzel, Orsini-Wappen, Details von Altargemälden und das Grab von General Conte Resta. Der in Deutschland geborene Fotograf und Gelehrte Max Hutzel (1911–1988) fotografierte in Italien von den frühen 1960er Jahren bis zu seinem Tod. Das Ergebnis

RMTBB1T7–Die John PEPERA SAMMLUNG, SS-Obergruppenführer August Heissmeyer - ein übereinstimmendes Paar der Goldenen Partei Abzeichen der NSDAP, Deschler produziert 30 mm vergoldete Tombak mit Einfügung Versilbert emailliert Partei Abzeichen. Partei die Nummer "21573" auf der Rückseite mit vertikalen Pin. Gestempelt incuse' GES. GESCH." über Kanal- und Entlüftungsöffnung. 24 mm der gleichen Bau, den Zustand und die entsprechende Nummer auf der Rückseite mit horizontalen Stift. Anhang Typenschild 'Jos. Fuess München'. August Heissmeyer (oder Heißmeyer - 11 Januar 1897 in Gellersen - 16 Januar 1979 in Schwäbisch Hall), war einer der führenden Memb, Editorial-Use - Nur

RMRCDG23–. Die stoffliche Grundlage der Vererbung. Vererbung ist. 34 III. Kapitel V - " ^..^Y a h. c^ ss ^d^4^^i^e^%. iX% - •^'/f i s^J r^^^".> *^r^^.. Bitte beachten Sie, dass diese Bilder sind von der gescannten Seite Bilder, die digital für die Lesbarkeit verbessert haben mögen - Färbung und Aussehen dieser Abbildungen können nicht perfekt dem Original ähneln. extrahiert. Morgan, Thomas Hunt, 1866-1945; Nachtsheim, Hans, 1890-1979. Borntraeger Berlin: G.

RM2WT3XT9–Abruzzen L'Aquila Tagliacozzo SS. Cosma e Damiano4. Hutzel, Max 1960-1990 Außenansicht: Fassade (15. Jahrhundert), Portal zum Innenhof (1452), Fassadenportale und Fenster. Innenansicht: Rippengewölbe, barocke Altäre an den Seiten der kreuzförmigen Kirche, Apsfresko, vergoldetes barockes Tabernakel in Form eines Tempels (18. Jahrhundert), Tabernakelstatuen, Kanzel, Orsini-Wappen, Details von Altargemälden und das Grab von General Conte Resta. Der in Deutschland geborene Fotograf und Gelehrte Max Hutzel (1911–1988) fotografierte in Italien von den frühen 1960er Jahren bis zu seinem Tod. Das Ergebnis
![. Verbreitung und Häufigkeit Trends von 22 ausgewählten Arten im mittleren Atlantik Bucht von Grundschleppnetzen Besichtigungen während 1967-1979: Abschlussbericht an den US-Mineral [s] Management Service. Fische-- Mid-Atlantic Golf geographische Verteilung; Fischpopulationen - Mid-Atlantic Bucht. NMFS/NEFC-WOQQS LOCH UNTEN LfiBGRATflRT TRflWL UMFRAGE CfiTCH Dh "F0U R S P 0 ICH FLO U N D ER KÜSTENNAHE / DER "SHORE FRÜHJAHR 196 S-L979 4a SS. ≪r^Jahre 00,^JT, Ba i Ft 0 5. iPf^^^. i--y/i i â' o * o ,1-' o - o - s - wenn -> v: vi ' " ' 1 '-l o. ,, T, J ICH. g< • o "0. Â" Ich 4 V^. 0 n° 0, wenn Stockfoto . Verbreitung und Häufigkeit Trends von 22 ausgewählten Arten im mittleren Atlantik Bucht von Grundschleppnetzen Besichtigungen während 1967-1979: Abschlussbericht an den US-Mineral [s] Management Service. Fische-- Mid-Atlantic Golf geographische Verteilung; Fischpopulationen - Mid-Atlantic Bucht. NMFS/NEFC-WOQQS LOCH UNTEN LfiBGRATflRT TRflWL UMFRAGE CfiTCH Dh "F0U R S P 0 ICH FLO U N D ER KÜSTENNAHE / DER "SHORE FRÜHJAHR 196 S-L979 4a SS. ≪r^Jahre 00,^JT, Ba i Ft 0 5. iPf^^^. i--y/i i â' o * o ,1-' o - o - s - wenn -> v: vi ' " ' 1 '-l o. ,, T, J ICH. g< • o "0. Â" Ich 4 V^. 0 n° 0, wenn Stockfoto](https://c8.alamy.com/compde/rccgep/verbreitung-und-haufigkeit-trends-von-22-ausgewahlten-arten-im-mittleren-atlantik-bucht-von-grundschleppnetzen-besichtigungen-wahrend-1967-1979-abschlussbericht-an-den-us-mineral-s-management-service-fische-mid-atlantic-golf-geographische-verteilung-fischpopulationen-mid-atlantic-bucht-nmfsnefc-woqqs-loch-unten-lfibgratflrt-trflwl-umfrage-cfitch-dh-f0u-r-s-p-0-ich-flo-u-n-d-er-kustennahe-der-shore-fruhjahr-196-s-l979-4a-ss-ltrjahre-00jt-ba-i-ft-0-5-ipf-i-yi-i-o-o-1-o-o-s-wenn-gt-v-vi-1-l-o-t-j-ich-glt-o-0-ich-4-v-0-n-0-wenn-rccgep.jpg)
RMRCCGEP–. Verbreitung und Häufigkeit Trends von 22 ausgewählten Arten im mittleren Atlantik Bucht von Grundschleppnetzen Besichtigungen während 1967-1979: Abschlussbericht an den US-Mineral [s] Management Service. Fische-- Mid-Atlantic Golf geographische Verteilung; Fischpopulationen - Mid-Atlantic Bucht. NMFS/NEFC-WOQQS LOCH UNTEN LfiBGRATflRT TRflWL UMFRAGE CfiTCH Dh "F0U R S P 0 ICH FLO U N D ER KÜSTENNAHE / DER "SHORE FRÜHJAHR 196 S-L979 4a SS. ≪r^Jahre 00,^JT, Ba i Ft 0 5. iPf^^^. i--y/i i â' o * o ,1-' o - o - s - wenn -> v: vi ' " ' 1 '-l o. ,, T, J ICH. g< • o "0. Â" Ich 4 V^. 0 n° 0, wenn

RM2WT4MBT–Abruzzen L'Aquila Tagliacozzo SS. Cosma e Damiano6. Hutzel, Max 1960-1990 Außenansicht: Fassade (15. Jahrhundert), Portal zum Innenhof (1452), Fassadenportale und Fenster. Innenansicht: Rippengewölbe, barocke Altäre an den Seiten der kreuzförmigen Kirche, Apsfresko, vergoldetes barockes Tabernakel in Form eines Tempels (18. Jahrhundert), Tabernakelstatuen, Kanzel, Orsini-Wappen, Details von Altargemälden und das Grab von General Conte Resta. Der in Deutschland geborene Fotograf und Gelehrte Max Hutzel (1911–1988) fotografierte in Italien von den frühen 1960er Jahren bis zu seinem Tod. Das Ergebnis
![. Verbreitung und Häufigkeit Trends von 22 ausgewählten Arten im mittleren Atlantik Bucht von Grundschleppnetzen Besichtigungen während 1967-1979: Abschlussbericht an den US-Mineral [s] Management Service. Fische-- Mid-Atlantic Golf geographische Verteilung; Fischpopulationen - Mid-Atlantic Bucht. NMFS/NEFC-WOQQS LOCH UNTEN LfiBGRATflRT TRflWL UMFRAGE CfiTCH Dh "F0U R S P 0 ICH FLO U N D ER KÜSTENNAHE / DER "SHORE FRÜHJAHR 196 S-L979 4a SS. ≪r^Jahre 00,^JT, Ba i Ft 0 5. iPf^^^. i--y/i i â' o * o ,1-' o - o - s - wenn -> v: vi ' " ' 1 '-l o. ,, T, J ICH. g< • o "0. Â" Ich 4 V^. 0 n° 0, wenn Stockfoto . Verbreitung und Häufigkeit Trends von 22 ausgewählten Arten im mittleren Atlantik Bucht von Grundschleppnetzen Besichtigungen während 1967-1979: Abschlussbericht an den US-Mineral [s] Management Service. Fische-- Mid-Atlantic Golf geographische Verteilung; Fischpopulationen - Mid-Atlantic Bucht. NMFS/NEFC-WOQQS LOCH UNTEN LfiBGRATflRT TRflWL UMFRAGE CfiTCH Dh "F0U R S P 0 ICH FLO U N D ER KÜSTENNAHE / DER "SHORE FRÜHJAHR 196 S-L979 4a SS. ≪r^Jahre 00,^JT, Ba i Ft 0 5. iPf^^^. i--y/i i â' o * o ,1-' o - o - s - wenn -> v: vi ' " ' 1 '-l o. ,, T, J ICH. g< • o "0. Â" Ich 4 V^. 0 n° 0, wenn Stockfoto](https://c8.alamy.com/compde/rccgr9/verbreitung-und-haufigkeit-trends-von-22-ausgewahlten-arten-im-mittleren-atlantik-bucht-von-grundschleppnetzen-besichtigungen-wahrend-1967-1979-abschlussbericht-an-den-us-mineral-s-management-service-fische-mid-atlantic-golf-geographische-verteilung-fischpopulationen-mid-atlantic-bucht-nmfsnefc-woqqs-loch-unten-lfibgratflrt-trflwl-umfrage-cfitch-dh-f0u-r-s-p-0-ich-flo-u-n-d-er-kustennahe-der-shore-fruhjahr-196-s-l979-4a-ss-ltrjahre-00jt-ba-i-ft-0-5-ipf-i-yi-i-o-o-1-o-o-s-wenn-gt-v-vi-1-l-o-t-j-ich-glt-o-0-ich-4-v-0-n-0-wenn-rccgr9.jpg)
RMRCCGR9–. Verbreitung und Häufigkeit Trends von 22 ausgewählten Arten im mittleren Atlantik Bucht von Grundschleppnetzen Besichtigungen während 1967-1979: Abschlussbericht an den US-Mineral [s] Management Service. Fische-- Mid-Atlantic Golf geographische Verteilung; Fischpopulationen - Mid-Atlantic Bucht. NMFS/NEFC-WOQQS LOCH UNTEN LfiBGRATflRT TRflWL UMFRAGE CfiTCH Dh "F0U R S P 0 ICH FLO U N D ER KÜSTENNAHE / DER "SHORE FRÜHJAHR 196 S-L979 4a SS. ≪r^Jahre 00,^JT, Ba i Ft 0 5. iPf^^^. i--y/i i â' o * o ,1-' o - o - s - wenn -> v: vi ' " ' 1 '-l o. ,, T, J ICH. g< • o "0. Â" Ich 4 V^. 0 n° 0, wenn
![. Verbreitung und Häufigkeit Trends von 22 ausgewählten Arten im mittleren Atlantik Bucht von Grundschleppnetzen Besichtigungen während 1967-1979: Abschlussbericht an den US-Mineral [s] Management Service. Fische-- Mid-Atlantic Golf geographische Verteilung; Fischpopulationen - Mid-Atlantic Bucht. 1 z 3 -3> - ≪2 IB K sS •: o*-cc ≪5 03 UJ u z O z. / - O O 0. UJ 03 o D-3 1 - Viva - Viva - Viva - Viva auf - o o o U3: o o o CO o in CN O" D O v CM uj o o o o m 1/1 3cr e ai' a fi • O kf) T3f^3 en0) i/l a. Bei c 0) r-â"¢^ (- 2 Is C â" 3s BJ. o • •.-Cj a â a-* c s Stockfoto . Verbreitung und Häufigkeit Trends von 22 ausgewählten Arten im mittleren Atlantik Bucht von Grundschleppnetzen Besichtigungen während 1967-1979: Abschlussbericht an den US-Mineral [s] Management Service. Fische-- Mid-Atlantic Golf geographische Verteilung; Fischpopulationen - Mid-Atlantic Bucht. 1 z 3 -3> - ≪2 IB K sS •: o*-cc ≪5 03 UJ u z O z. / - O O 0. UJ 03 o D-3 1 - Viva - Viva - Viva - Viva auf - o o o U3: o o o CO o in CN O" D O v CM uj o o o o m 1/1 3cr e ai' a fi • O kf) T3f^3 en0) i/l a. Bei c 0) r-â"¢^ (- 2 Is C â" 3s BJ. o • •.-Cj a â a-* c s Stockfoto](https://c8.alamy.com/compde/rccy6p/verbreitung-und-haufigkeit-trends-von-22-ausgewahlten-arten-im-mittleren-atlantik-bucht-von-grundschleppnetzen-besichtigungen-wahrend-1967-1979-abschlussbericht-an-den-us-mineral-s-management-service-fische-mid-atlantic-golf-geographische-verteilung-fischpopulationen-mid-atlantic-bucht-1-z-3-3gt-lt2-ib-k-ss-o-cc-lt5-03-uj-u-z-o-z-o-o-0-uj-03-o-d-3-1-viva-viva-viva-viva-auf-o-o-o-u3-o-o-o-co-o-in-cn-o-d-o-v-cm-uj-o-o-o-o-m-11-3cr-e-ai-a-fi-o-kf-t3f3-en0-il-a-bei-c-0-r-2-is-c-3s-bj-o-cj-a-a-c-s-rccy6p.jpg)
RMRCCY6P–. Verbreitung und Häufigkeit Trends von 22 ausgewählten Arten im mittleren Atlantik Bucht von Grundschleppnetzen Besichtigungen während 1967-1979: Abschlussbericht an den US-Mineral [s] Management Service. Fische-- Mid-Atlantic Golf geographische Verteilung; Fischpopulationen - Mid-Atlantic Bucht. 1 z 3 -3> - ≪2 IB K sS •: o*-cc ≪5 03 UJ u z O z. / - O O 0. UJ 03 o D-3 1 - Viva - Viva - Viva - Viva auf - o o o U3: o o o CO o in CN O" D O v_CM uj o o o o m 1/1 3cr e ai'_a fi • O kf) T3f^3 en0) i/l a. Bei c 0) r-â"¢^ (- 2 Is C â" 3s BJ. o • •.-Cj a â a-* c s

RMRD3J2J–. Datum wachsen in die Alte und die Neue. Datum Palm. ≪-w • - <a fJ.2-:°°°°°° SS H S 3. Bitte beachten Sie, dass diese Bilder sind von der gescannten Seite Bilder, die digital für die Lesbarkeit verbessert haben mögen - Färbung und Aussehen dieser Abbildungen können nicht perfekt dem Original ähneln. extrahiert. Popenoe, Paul Bowman, 1888-1979; Bennett, Charles L. Altadena, cal. , West Indien Gärten













